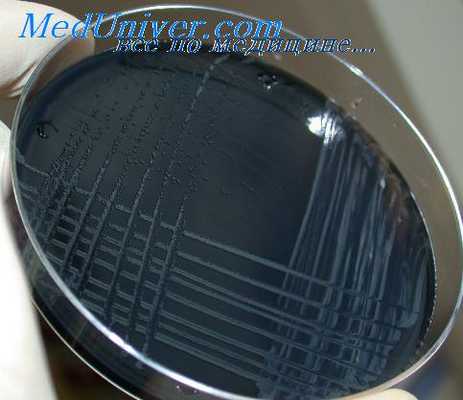
кампилобактериоз

Клиника и проявления кампилобактериоза. Лечение и профилактика кампилобактериоза
Добавил пользователь Евгений Кузнецов Обновлено: 11.12.2025
Бремя болезней пищевого происхождения, включая кампилобактериоз, весьма значительно: ежегодно заболевает почти каждый десятый человек, что приводит к потере 33 миллионов лет здоровой жизни. Болезни пищевого происхождения могут быть тяжелыми, особенно у детей раннего возраста. Диарейные болезни — наиболее распространенные заболевания, вызванные небезопасной пищей. Ими ежегодно заболевает 550 миллионов человек (в том числе 220 миллионов детей младше 5 лет). Campylobacter является одной из четырех основных причин диарейных болезней во всем мире.
В связи с широкой распространенностью диареи, вызванной бактериями Campylobacter, а также ее продолжительностью и возможными осложнениями, ее социально-экономическое значение весьма велико. В развивающихся странах инфекции Campylobacter особенно часто встречаются у детей младше 2 лет, причем иногда они заканчиваются летальным исходом.
Бактерии Campylobacter имеют преимущественно спиралевидную, S-образную или изогнутую, палочкообразную форму. В настоящее время к роду Campylobacter относят 17 видов и 6 подвидов, из которых наиболее часто вызывают заболевания у людей C. jejuni (подвид jejuni) и C. coli. У пациентов с диарейными заболеваниями были изолированы и другие виды, такие как C. lari и C. upsaliensis, но эти виды регистрируются реже.
Заболевание
Кампилобактериоз — заболевание, которое вызывается инфицированием бактерией Campylobacter.
Источники и передача инфекции
Виды Campylobacter широко распространены среди большинства теплокровных животных. Они часто встречаются в организме животных, продукты которых используются в пищу, таких как домашняя птица, крупный рогатый скот, свиньи, овцы и страусы, а также у домашних животных, включая кошек и собак. Кроме того, эти бактерии были обнаружены у моллюсков.
Считается, что инфекция передается в основном пищевым путем — через мясо и мясные продукты, прошедшие недостаточную тепловую обработку, а также через сырое или загрязненное молоко. Загрязненные вода или лед также являются источником инфекции. Определенная доля случаев заболевания бывает вызвана контактом с загрязненной водой во время рекреационных мероприятий.
Кампилобактериоз является зоонозом — болезнью, передаваемой человеку от животных или из продуктов животного происхождения. Чаще всего туши или мясо загрязняются Campylobacter из фекалий во время забоя. При этом у животных Campylobacter редко приводит к заболеваниям.
Относительное значение каждого из вышеперечисленных источников для общего бремени болезни неизвестно, но основным фактором считается потребление зараженного мяса домашней птицы, прошедшего недостаточную тепловую обработку. Поскольку на вспышки болезни, связанные с общим источником инфекции, приходится довольно незначительная процентная доля случаев, подавляющее большинство случаев заболевания регистрируется как спорадические, без четко прослеживаемых моделей.
Следовательно, оценить значимость всех известных источников инфекции чрезвычайно сложно. Кроме того, широкая распространенность Campylobacter затрудняет разработку стратегий борьбы с инфекцией на протяжении всей продовольственной цепи. Тем не менее, в странах, где применяются целенаправленные стратегии по уменьшению распространенности Campylobacter среди живой домашней птицы, наблюдается аналогичное уменьшение случаев заболевания среди людей.
Лечение
Лечения, как правило, не требуется, за исключением возмещения электролитов и регидратации. Противомикробная терапия рекомендуется в инвазивных случаях (когда бактерии проникают в клетки слизистой оболочки кишечника и разрушают ткани) или для ликвидации состояния носительства (состояние людей, являющихся носителями Campylobacter и выделяющих бактерии, но не обнаруживающих симптомов заболевания).
Методы профилактики
Существует ряд стратегий, которые могут использоваться для профилактики болезни, вызванной бактериями Campylobacter:
- Профилактика основывается на контрольных мерах во всех звеньях пищевой цепи — от сельскохозяйственного производства до обработки, производства и приготовления пищевых продуктов как с коммерческой целью, так и в домашних условиях.
- В странах, где отсутствуют надлежащие системы канализации, возможно, будет необходимо дезинфицировать фекалии и продукты, загрязненные фекалиями, перед утилизацией.
- Меры по сокращению распространенности Campylobacter среди домашней птицы включают в себя укрепление биобезопасности во избежание передачи Campylobacter из окружающей среды поголовью птиц на ферме. Эта мера контроля осуществима только в том случае, если птицы содержатся в закрытом помещении.
- Практика забоя с соблюдением надлежащих правил гигиены позволяет сократить загрязнение тушек фекалиями, но не гарантирует отсутствие бактерий Campylobacter в мясе и мясопродуктах. Чтобы свести загрязнение к минимуму, чрезвычайно важна подготовка работников, осуществляющих забой животных, и производителей сырого мяса в области гигиенической обработки и приготовления пищевых продуктов.
- Профилактические меры защиты от инфекции на домашней кухне схожи с мерами, принимаемыми для защиты от других бактериальных болезней пищевого происхождения.
- Единственным эффективным методом уничтожения Campylobacter в зараженных пищевых продуктах является бактерицидная обработка, такая как нагревание (например, приготовление пищи посредством тепловой обработки или пастеризация) или облучение.
Деятельность ВОЗ
В сотрудничестве с другими заинтересованными сторонами ВОЗ решительно отстаивает важную роль безопасности пищевых продуктов как одной из ключевых составляющих обеспечения доступа к безопасной и питательной диете. ВОЗ разрабатывает меры политики и рекомендации, охватывающие всю пищевую цепь от производства до потребления, опираясь при этом на разные виды экспертных знаний и опыта в различных областях.
ВОЗ работает над укреплением систем обеспечения безопасности пищевых продуктов во все более глобализованном мире. Установление международных стандартов безопасности пищевых продуктов, повышение качества эпиднадзора за болезнями, просвещение потребителей и подготовка лиц, занимающихся обработкой и приготовлением пищевых продуктов, в области безопасного обращения с пищевыми продуктами входят в число важнейших способов предотвращения болезней пищевого происхождения.
В сотрудничестве с Продовольственной и сельскохозяйственной Организацией Объединенных Наций (ФАО), Всемирной организацией здравоохранения животных (МЭБ) и Сотрудничающим центром ВОЗ при университете Утрехта ВОЗ в 2012 г. опубликовала доклад «Глобальный обзор по кампилобактериозу» (The global view of campylobacteriosis).
ВОЗ укрепляет потенциал национальных и региональных лабораторий в области эпиднадзора за патогенами пищевого происхождения, такими как Campylobacter и Salmonella.
Кроме того, ВОЗ способствует комплексному эпиднадзору за устойчивостью патогенов, присутствующих в пищевой цепи, к противомикробным препаратам, собирая образцы у людей и животных и образцы пищевых продуктов и анализируя данные, полученные в разных секторах.
ВОЗ совместно с ФАО оказывает помощь государствам-членам, координируя международные усилия по раннему выявлению вспышек болезней пищевого происхождения и соответствующим ответным мерам через сеть национальных органов в государствах-членах.
Кроме того, ВОЗ осуществляет научную оценку, которая используется в качестве основы для разрабатываемых Комиссией ФАО/ВОЗ по Кодекс алиментариус международных стандартов, принципов и рекомендаций в отношении пищевых продуктов для профилактики болезней пищевого происхождения.
Рекомендации для населения и лиц, совершающих поездки
Обеспечить безопасность во время поездок помогут следующие рекомендации:
- Обеспечить, чтобы пищевые продукты прошли надлежащую тепловую обработку и были все еще горячими при их подаче.
- Избегать употребления сырого молока и продуктов, приготовленных из сырого молока. Пить только пастеризованное или кипяченое молоко.
- Избегать употребления льда, если только он не был изготовлен из безопасной воды.
- Употребляйте лед только в том случае, когда он сделан из безопасной воды.
- При наличии сомнения в безопасности воды, прокипятить ее или, если это невозможно, продезинфицировать ее с помощью какого-либо надежного дезинфицирующего вещества медленного действия (обычно такие вещества можно приобрести в аптеках).
- Тщательно мыть руки и часто использовать мыло, особенно после контактов с домашними или сельскохозяйственными животными, а также после посещения туалета.
- Тщательно мыть фрукты и овощи, особенно при их потреблении в сыром виде. По возможности снимать кожуру с овощей и фруктов.
- Руководство по безопасным пищевым продуктам для туристов
Рекомендации для лиц, занимающихся обработкой и приготовлением пищевых продуктов
ВОЗ сформулировала следующие рекомендации для лиц, занимающихся обработкой и приготовлением пищевых продуктов:
Клиника и проявления кампилобактериоза. Лечение и профилактика кампилобактериоза
Инкубационный период 1-6 дней (чаще 1-2 дня), иногда более продолжительный. Почти у половины больных поражению кишечника предшествуют непродолжительные продромальные явления (недомогание, слабость, повышение температуры, головная боль, миалгии, артралгии). По клиническому течению различают следующие формы болезни: 1) гастроинтестинальную; 2) генерализованную (септическую); 3) субклиническую; 4) хроническую, а также ассоциированные его формы с другими хроническими заболеваниями ЖКТ (гастрит, язвы желудка и двенадцатиперстной кишки). В последние годы они стали предметом пристального изучения гастроэнтерологов, которые склонны связывать этиологию этих заболеваний только с обнаружением Н. pylori.
Гастроинтестинальная форма проявляется острым началом болезни, лихорадкой, симптомами общей интоксикации и развитием, чаще всего острого гастроэнтерита; у больных появляется тошнота, боль в эпигастральной области, иногда рвота. Стул обильный, жидкий, пенистый. Прогрессирование болезни ведет к развитию обезвоживания, появлению судорог. У детей в стуле возможно присутствие крови и слизи. Реже заболевание протекает по типу энтероколита и колита; в этих случаях клиника кампилобактериоза имеет сходное течение с дизентерией.
Генерализованная (септическая) форма протекает с выраженной лихорадкой, большими суточными колебаниями температуры, снижением массы тела, анемией, бактериемией, полиорганными поражениями. У больных часто отмечается рвота, понос, развитие абсцессов различной локализации (головной мозг, печень, почки, легкие, миокард и др.), развивается тромбогеморрагический синдром и ИТШ.

Хроническая форма кампилобактериоза отличается вялым началом болезни и длительным волнообразным течением. Больные отмечают субфебрилитет, слабость, снижение массы тела. Понос чередуется с запором. Иногда развиваются конъюнктивиты, артриты, тромбофлебиты, эндокардит, перикардит, плевриты. По течению болезнь может напоминать хрониосепсис.
Субклиническая (бессимптомная) форма кампилобактериоза проявляется выделением возбудителя из испражнений и крови и образованием специфических антител. Обычно эта форма кампилобактериоза выявляется среди здоровых лиц, находившихся в общении с больными.
В связи с большим клиническим полиморфизмом кампилобактериоза и схожестью со многими заболеваниями распознавание его возможно только при выделении возбудителя из испражнений, крови и воспалительных экссудатов. Дополнительное диагностическое значение может иметь постановка различных серологических реакций (РА, РСК, РПГА, ИФА и др.) и определение титра специфических антител в динамике болезни.
Лечение и профилактика кампилобактериоза
Этиотропное лечение проводится только при клинически выраженных формах, сопровождающихся лихорадкой, болью в животе, диарейным синдромом. При легком течении болезни ограничиваются симптоматическими средствами. При кампилобактериозе наиболее эффективными являются эритромицин, доксициклин, левомицетин, аминогликозиды, нитрофураны в обычных терапевтических дозах. Курс лечения не менее 7 дней. В ряде случаев требуется повторное курсовое назначение антибиотиков со сменой препарата. Лечение септических форм кампилобактериоза осуществляется по программе лечения сепсиса. При симптомах обезвоживания проводят регидратационную терапию полиионными растворами, как это принято при лечении пищевых токсикоинфекций и холеры. При обнаружении Helicobacter pylori проводят курсовое лечение по специальным схемам, принятым в гастроэнтерологии.
Кампилобактериоз распространен во всех странах. В России встречается на северо-западе Европейской части, в Поволжье, Западной Сибири и других регионах. В современной этиологической структуре диарейных заболеваний кампилобактериозу принадлежит 5-10%. Наблюдаются спорадические заболевания и описаны эпидемические вспышки, связанные с употреблением зараженных сырой воды и молока.
Источником инфекции и ее резервуаром в природе являются многие виды животных, включая домашних. Носительство С. febus jejuni обнаружено у кроликов (11-13%), кошек (30-45%) и особенно уток (более 80%). Не исключают заражение от человека при инфицировании новорожденных детей. Бактерионосительство у здоровых людей не превышает 1%. Возможно заражение при уходе за животными, употреблении недостаточно термически обработанного мяса, молока. Частота заболеваний возрастает в летние месяцы. Путь передачи инфекции - фекально-оральный. Допускают возможность заражения людей при тесном бытовом общении с лицами, страдающими болезнями, ассоциированными с Helicobacter pylori.
Профилактика включает меры, направленные на соблюдение санитарно-гигиенических условий при забое животных, приготовлении мясных блюд. Специфическая профилактика не разработана. Больные кампилобактериозом не представляют большой опасности для окружающих. Госпитализация больных проводится по клиническим показаниям. Наблюдение за переболевшими людьми проводят врачи-инфекционисты КИЗ поликлиник.
Информация на сайте подлежит консультации лечащим врачом и не заменяет очной консультации с ним.
См. подробнее в пользовательском соглашении.
Кишечная инфекция у детей
Кишечная инфекция у детей – группа инфекционных заболеваний различной этиологии, протекающих с преимущественным поражением пищеварительного тракта, токсической реакцией и обезвоживанием организма. У детей кишечная инфекция проявляется повышением температуры тела, вялостью, отсутствием аппетита, болями в животе, рвотой, диареей. Диагностика кишечной инфекции у детей основана на клинико-лабораторных данных (анамнезе, симптоматике, выделении возбудителя в испражнениях, обнаружении специфических антител в крови). При кишечной инфекции у детей назначаются антимикробные препараты, бактериофаги, энтеросорбенты; в период лечения важно соблюдение диеты и проведение регидратации.
Общие сведения
Кишечная инфекция у детей – острые бактериальные и вирусные инфекционные заболевания, сопровождающиеся кишечным синдромом, интоксикацией и дегидратацией. В структуре инфекционной заболеваемости в педиатрии кишечные инфекции у детей занимают второе место после ОРВИ. Восприимчивость к кишечной инфекции у детей в 2,5-3 раза выше, чем у взрослых. Около половины случаев кишечной инфекции у детей приходится на ранний возраст (до 3 лет). Кишечная инфекция у ребенка раннего возраста протекает тяжелее, может сопровождаться гипотрофией, развитием дисбактериоза и ферментативной недостаточности, снижением иммунитета. Частое повторение эпизодов инфекции вызывает нарушение физического и нервно-психического развития детей.
Причины
Спектр возбудителей кишечных инфекций у детей крайне широк. Наиболее часто патогенами выступают грамотрицательные энтеробактерии (шигеллы, сальмонеллы, кампилобактеры, эшерихии, иерсинии) и условно-патогенная флора (клебсиеллы, клостридии, протей, стафилококки и др.). Кроме этого, встречаются кишечные инфекции, вызываемые вирусными возбудителями (ротавирусами, энтеровирусами, аденовирусами), простейшими (лямблиями, амебами, кокцидиями), грибами. Общими свойствами всех возбудителей, обусловливающих развитие клинических проявлений, являются энтеропатогенность, способность к синтезу эндо- и экзотоксинов.
Заражение детей кишечными инфекциями происходит посредством фекально-орального механизма алиментарным (через пищу), водным, контактно-бытовым путями (через посуду, грязные руки, игрушки, предметы обихода и т. д.). У ослабленных детей с низкой иммунологической реактивностью возможно эндогенное инфицирование условно-патогенными бактериями. Источником ОКИ может выступать носитель, больной со стертой или манифестной формой заболевания, домашние животные. В развитии кишечной инфекции у детей большую роль играет нарушение правил приготовления и хранения пищи, допуск на детские кухни лиц-носителей инфекции, больных тонзиллитом, фурункулезом, стрептодермией и пр.
Наиболее часто регистрируются спорадические случаи кишечной инфекции у детей, хотя при пищевом или водном пути инфицирования возможны групповые и даже эпидемические вспышки. Подъем заболеваемости некоторыми кишечными инфекциями у детей имеет сезонную зависимость: так, дизентерия чаще возникает летом и осенью, ротавирусная инфекция - зимой.
Распространенность кишечных инфекций среди детей обусловлена эпидемиологическими особенностями (высокой распространенностью и контагиозностью возбудителей, их высокой устойчивостью к факторам внешней среды), анатомо-физиологическими особенностями пищеварительной системы ребенка (низкой кислотностью желудочного сока), несовершенством защитных механизмов (низкой концентрацией IgA). Заболеваемости детей острой кишечной инфекцией способствует нарушение нормальной микробиоты кишечника, несоблюдение правил личной гигиены, плохие санитарно-гигиенические условия жизни.
Классификация
По клинико-этиологическому принципу среди кишечных инфекций, наиболее часто регистрируемых в детской популяции, выделяют шигеллез (дизентерию), сальмонеллез, коли-инфекцию (эшерихиозы), иерсиниоз, кампилобактериоз, криптоспоридиоз, ротавирусную инфекцию, стафилококковую кишечную инфекцию и др.
По тяжести и особенностям симптоматики течение кишечной инфекции у детей может быть типичным (легким, средней тяжести, тяжелым) и атипичным (стертым, гипертоксическим). Выраженность клиники оценивается по степени поражения ЖКТ, обезвоживания и интоксикации.
Характер местных проявлений при кишечной инфекции у детей зависит от поражения того или иного отдела ЖКТ, в связи с чем выделяют гастриты, энтериты, колиты, гастроэнтериты, гастроэнтероколиты, энтероколиты. Кроме локализованных форм, у грудных и ослабленных детей могут развиваться генерализованные формы инфекции с распространением возбудителя за пределы пищеварительного тракта.
В течении кишечной инфекции у детей выделяют острую (до 1,5 месяцев), затяжную (свыше 1,5 месяцев) и хроническую (свыше 5-6 месяцев) фазы.
Симптомы у детей
Дизентерия у детей
После непродолжительного инкубационного периода (1-7 суток) остро повышается температура (до 39-40° C), нарастает слабость и разбитость, снижается аппетит, возможна рвота. На фоне лихорадки отмечается головная боль, ознобы, иногда – бред, судороги, потеря сознания. Кишечная инфекция у детей сопровождается схваткообразными болями в животе с локализацией в левой подвздошной области, явлениями дистального колита (болезненностью и спазмом сигмовидной кишки, тенезмами с выпадением прямой кишки), симптомами сфинктерита. Частота дефекации может варьировать от 4-6 до 15-20 раз за сутки. При дизентерии стул жидкий, содержащий примеси мутной слизи и крови. При тяжелых формах дизентерии возможно развитие геморрагического синдрома, вплоть до кишечного кровотечения.
У детей раннего возраста при кишечной инфекции общая интоксикация преобладает над колитическим синдромом, чаще возникают нарушения гемодинамики, электролитного и белкового обмена. Наиболее легко у детей протекает кишечная инфекция, вызванная шигеллами Зоне; тяжелее - шигеллами Флекснера и Григорьеза-Шига.
Сальмонеллез у детей
Наиболее часто (в 90% случаев) развивается желудочно-кишечная форма сальмонеллеза, протекающая по типу гастрита, гастроэнтерита, гастроэнтероколита. Характерно подострое начало, фебрильный подъем температуры, адинамия, рвота, гепатоспленомегалия. Стул при сальмонеллезе жидкий, обильный, каловый, цвета «болотной тины», с примесями слизи и крови. Обычно данная форма кишечной инфекции заканчивается выздоровлением, однако у грудных детей возможен летальный исход вследствие тяжелого кишечного токсикоза.
Гриппоподобная (респираторная) форма кишечной инфекции встречается у 4-5% детей. При данной форме сальмонеллы обнаруживаются в посеве материала из зева. Ее течение характеризуется фебрильной температурой, головной болью, артралгией и миалгией, явлениями ринита, фарингита, конъюнктивита. Со стороны сердечно-сосудистой системы отмечаются тахикардия и артериальная гипотония.
На тифоподобную форму сальмонеллеза у детей приходится 2% клинических случаев. Она протекает с длительным периодом лихорадки (до 3-4-х недель), выраженной интоксикацией, нарушением функции сердечно-сосудистой системы (тахикардией, брадикардией).
Септическая форма кишечной инфекции обычно развивается у детей первых месяцев жизни, имеющих неблагоприятный преморбидный фон. На ее долю приходится около 2-3% случаев сальмонеллеза у детей. Заболевание протекает крайне тяжело, сопровождается септицемией или септикопиемией, нарушением всех видов обмена, развитием тяжелых осложнений (пневмонии, паренхиматозного гепатита, отоантрита, менингита, остеомиелита).
Эшерихиозы у детей
Данная группа кишечных инфекций у детей крайне обширна и включает коли-инфекци, вызываемые энтеропатогенными, энтеротоксигенными, энтероинвазивными, энтерогеморрагическими эшерихиями.
Кишечная инфекция у детей, вызванная эшерихиями, протекает с субфебрильной или фебрильной температурой, слабостью, вялостью, снижением аппетита, упорной рвотой или срыгиваниями, метеоризмом. Характерна водянистая диарея (обильный, брызжущий стул желтого цвета с примесью слизи), быстро приводящая к дегидратации и развитию эксикоза. При эшерихиозе, вызываемом энтерогеморрагическими эшерихиями, диарея носит кровавый характер.
Вследствие обезвоживания у ребенка возникает сухость кожи и слизистых оболочек, снижается тургор и эластичность тканей, западает большой родничок и глазные яблоки, снижается диурез по типу олигурии или анурии.
Ротавирусная инфекция у детей
Обычно протекает по типу острого гастроэнтерита или энтерита. Инкубационный период в среднем длится 1-3 дня. Все симптомы кишечной инфекции у детей разворачиваются в течение одних суток, при этом поражение ЖКТ сочетается с катаральными явлениями.
Респираторный синдром характеризуется гиперемией зева, ринитом, першением в горле, покашливанием. Одновременно с поражением носоглотки развиваются признаки гастроэнтерита: жидкий (водянистый, пенистый) стул с частотой дефекаций от 4-5 до 15 раз в сутки, рвотой, температурной реакцией, общей интоксикацией. Длительность течения кишечной инфекции у детей – 4-7 дней.
Стафилококковая кишечная инфекция у детей
Различают первичную стафилококковую кишечную инфекцию у детей, связанную с употреблением пищи, обсемененной стафилококком, и вторичную, обусловленную распространением возбудителя из других очагов.
Течение кишечной инфекции у детей характеризуется тяжелым эксикозом и токсикозом, рвотой, учащением стула до 10-15 раз в день. Стул жидкий, водянистый, зеленоватого цвета, с небольшой примесью слизи. При вторичной стафилококковой инфекции у детей кишечные симптомы развиваются на фоне ведущего заболевания: гнойного отита, пневмонии, стафилодермии, ангины и пр. В этом случае заболевание может принимать длительное волнообразное течение.
Диагностика
На основании осмотра, эпидемиологических и клинических данных педиатр (детский инфекционист) может лишь предположить вероятность кишечной инфекции у детей, однако этиологическая расшифровка возможна только на основании лабораторных данных.
Главную роль в подтверждении диагноза кишечной инфекции у детей играет бактериологическое исследование испражнений, которое следует проводить как можно ранее, до начала этиотропной терапии. При генерализованной форме кишечной инфекции у детей проводится посев крови на стерильность, бактериологическое исследование мочи, ликвора.
Определенную диагностическую ценность представляют серологические методы (РПГА, ИФА, РСК), позволяющие выявлять наличие Ат к возбудителю в крови больного с 5-х суток от начала болезни. Исследование копрограммы позволяет уточнить локализацию процесса в ЖКТ.
При кишечной инфекции у детей требуется исключить острый аппендицит, панкреатит, лактазную недостаточность, дискинезию желчевыводящих путей и др. патологию. С этой целью проводятся консультации детского хирурга и детского гастроэнтеролога.
Лечение кишечной инфекции у детей
Комплексное лечение кишечных инфекций у детей предполагает организацию лечебного питания; проведение оральной регидратации, этиотропной, патогенетической и симптоматической терапии.
Диета детей с кишечной инфекцией требует уменьшения объема питания, увеличения кратности кормлений, использования смесей, обогащенных защитными факторами, употребление протертой легкоусвояемой пищи. Важной составляющей терапии кишечных инфекций у детей является оральная регидратация глюкозо-солевыми растворами, обильное питье. Она проводится до прекращения потерь жидкости. При невозможности перорального питания и употребления жидкости назначается инфузионая терапия: внутривенно вводятся растворы глюкозы, Рингера, альбумина и др.
Этиотропная терапия кишечных инфекций у детей проводится антибиотиками и кишечными антисептиками (канамицин, гентамицин, полимиксин, фуразолидон, налидиксовая кислота), энтеросорбентами. Показан прием специфических бактериофагов и лактоглобулинов (сальмонеллезного, дизентерийного, колипротейного, клебсиеллезного и др.), а также иммуноглобулинов (антиротавирусного и др.). Патогенетическая терапия предполагает назначение ферментов, антигистаминных препаратов; симптоматическое лечение включает прием жаропонижающих, спазмолитиков. В период реконвалесценции необходима коррекция дисбактериоза, прием витаминов и адаптогенов.
Прогноз и профилактика
Раннее выявление и адекватная терапия обеспечивают полное выздоровление детей после кишечной инфекции. Иммунитет после ОКИ нестойкий. При тяжелых формах кишечной инфекции у детей возможно развитие гиповолемического шока, ДВС-синдрома, отека легких, острой почечной недостаточности, острой сердечной недостаточности, инфекционно-токсического шока.
В основе профилактики кишечных инфекций у детей – соблюдение санитарно-гигиенических норм: правильное хранение и термическая обработка продуктов, защита воды от загрязнения, изоляция больных, проведение дезинфекции игрушек и посуды в детских учреждениях, привитие детям навыков личной гигиены. При уходе за грудным ребенком мама не должна пренебрегать обработкой молочных желез перед кормлением, обработкой сосок и бутылочек, мытьем рук после пеленания и подмывания ребенка.
Дети, контактировавшие с больным кишечной инфекцией, подлежат бактериологическому обследованию и наблюдению в течение 7 дней.
Кампилобактериоз
Кампилобактериоз – острая зоонозная инфекция, вызываемая энтеробактериями Campylobacter и протекающая с преимущественным поражением пищеварительного тракта. Локализованная форма кампилобактериоза в большинстве случаев протекает по типу гастроэнтерита или гастроэнтероколита; генерализованная форма сопровождается развитием септицемии или септикопиемии. Диагноз кампилобактериоза подтверждается с помощью бактериологического посева кала, крови; серологических реакций, эндоскопии кишечника. Специфическая этиотропная терапия кампилобактериоза осуществляется противомикробными препаратами (метронидазолом, антибиотиками тетрациклинового ряда, групп макролидов или фторхинолонов и др.).
Кампилобактериоз – острая кишечная инфекция, возбудителями которой являются бактерии кампилобактеры. В структуре диарейных заболеваний на долю кампилобактериоза приходится 5-15%, что говорит о его распространенности и эпидемиологической значимости. Кампилобактериоз регистрируется во всех странах мира, в т. ч. в России; более высокий уровень заболеваемости отмечается в тропических широтах. Кампилобактериозом болеют представители различных возрастных групп, однако чаще инфекция диагностируется у детей-дошкольников. Возможно возникновение как спорадических, так и групповых случаев кишечной инфекции. Пик заболеваемости кампилобактериозом приходится на летне-осенние месяцы, с июня по сентябрь.
Причины кампилобактериоза
Кампилобактериоз вызывают патогенные виды кишечных бактерий, принадлежащие к семейству Enterobacteriaceae, роду Campylobacter. В настоящее время насчитывается более 14 видов кампилобактеров, выделенных от людей и животных. Наибольшую значимость в этиологии и патогенезе кампилобактериоза человека имеют C.coli, C.jejuni, C.laridis, C.fetus: из них первые два вида вызывают большинство случаев диарейных форм инфекции, а последний - гематогенно-диссеминированные формы заболевания.
Кампилобактеры являются грамотрицательными, не образующими спор бактериями, имеющими небольшие размеры (длина 0,5-0,8 мкм, ширина 0,2-0,5 мкм), изогнутую или спиралевидную форму. Подвижность бактерий обеспечивается одним или двумя жгутиками, расположенными полярно. Оптимальными условиями для роста кампилобактеров является микроаэрофильная среда с концентрацией кислорода не более 5-10% и температурой 37-42°С, однако бактерии устойчивы и к низким температурам.
Основным источником заражения человека кампилобактериозом служат сельскохозяйственные животные и птицы, а ведущим способом передачи возбудителей – алиментарный путь, реализуемый при употреблении загрязненных мясных продуктов, молока, воды. Реже возможно проникновение микроорганизмов через поврежденную кожу, например, при укусах инфицированных животных. Заражение новорожденных может происходить трансплацентарно или во время родов. В группе риска по возникновению кампилобактериоза находятся сельские жители, работники животноводческих и птицеводческих хозяйств, а также туристы, посещающие развивающиеся страны. В большей степени заболеваемости кампилобактериозом подвержены лица, страдающие иммунодефицитными состояниями, дети и беременные женщины.
При попадании в организм кампилобактеры достигают тонкой кишки, где внедряются в ее слизистую оболочку и лимфоидные образования, вызывая развитие воспалительного процесса различной выраженности. По лимфатическим путям кампилобактеры проникают в брыжеечные лимфоузлы, червеобразный отросток, толстый кишечник. В процессе своей жизнедеятельности кампилобактеры продуцируют энтеро- и цитотоксины, а при разрушении выделяют эндотоксины, обусловливающие развитие диарейного, болевого и интоксикационного синдромов. При переходе кампилобактериоза в генерализованную форму развивается септицемия и септикопиемия, приводящие к полиорганному поражению с возникновением абсцессов в печени и селезенке, полиартрита, лимфаденита, менингита, нефрита и др.
Классификация кампилобактериоза
На основании клинико-патогенетических особенностей различают локализованную (гастроинтестинальную) и генерализованная форму кампилобактериоза. К локализованным вариантам течения инфекции относятся гастроэнтерит, гастроэнтероколит, энтерит, энтероколит, мезаденит, аппендицит. Генерализованная форма сопровождается развитием кампилобактериозной септицемии и септикопиемии.
Кампилобактериоз может иметь манифестное или бессимптомное течение. Клинически выраженные формы включают легкую, среднетяжелую и тяжелую степени. Бессимптомные формы представлены субклиническим и реконвалесцентным вариантами кампилобактериоза. В зависимости от продолжительности инфекции различают острую (до 3 месяцев), хроническую (более 3 месяцев) и резидуальную фазу кампилобактериоза.
Симптомы кампилобактериоза
В большинстве случаев кампилобактериоз протекает в локализованной форме, принимая характер энтерита, энтероколита, гастроэнтероколита или колита. У заболевших часто имеются сопутствующие заболевания ЖКТ: гастриты, дуодениты, язвенная болезнь желудка и 12-перстной кишки, дискинезии желчевыводящих путей, холециститы.
Развитие генерализованных форм кампилобактериоза отмечается у лиц с неблагоприятным сопутствующим фоном: кахексией, циррозом печени, сахарным диабетом, туберкулезом, системными заболеваниями, злокачественными опухолями, ВИЧ-инфекцией, а также у детей первых месяцев жизни. Клиническая симптоматика включает стойкую лихорадку (до 40°С и выше), профузные поты, ознобы, истощение, диспепсические явления, гепатоспленомегалию, анемизацию. В некоторых случаях транзиторная бактериемия может прогрессировать в септический процесс, вызывая развитие гнойных метастатических очагов в различных органах в виде артрита, микрополилимфаденита, перитонита, эндокардита, миокардита, плеврита, пневмонии, менингита, энцефалита и др. Течение генерализованной формы кампилобактериоза тяжелое, нередко отмечается летальный исход.
Хронический кампилобактериоз обычно связан с иммунодепрессивными состояниями, в т. ч. ВИЧ-инфекцией. Больных беспокоит субфебрилитет, неустойчивый стул, боли в мезогастрии, снижение аппетита, похудание. Часто выявляются признаки конъюнктивита, кератита, фарингита; у женщин возникают рецидивирующие вагиниты или вульвовагиниты, выкидыши. В периоды обострения кампилобактериоза могут развиться органные поражения, характерные для генерализованной формы.
Диагностика кампилобактериоза
Основаниями для подозрения на кампилобактериоз могут служить эпиданамнез (контакт с животными, туристические поездки и др.), характерные симптомы. При исследовании копрограммы в испражнениях обнаруживается воспалительный экссудат, лейкоциты, эритроциты. Ректороманоскопия или колоноскопия в разгар заболевания выявляет картину катарального, катарально-геморрагического, эрозивно-язвенного проктосигмоидита или колита.
Самым точным подтверждением кампилобактериоза является бактериологическое исследование кала. Иногда материалом для культурального исследования служит кровь, гной абсцессов, ликвор, околоплодные воды. Также проводится серологическая диагностика с помощью методов РА, РНГА, РСК, ИФА, иммуноэлектрофореза, латекс-агглютинации и др.
Гастроинтестинальная форма кампилобактериоза требует дифференциации от других ОКИ, прежде всего дизентерии и сальмонеллеза, а также мезаденита и аппендицита другой этиологии. Эндоскопическая биопсия кишечника позволяет исключить неспецифический язвенный колит и болезнь Крона. Генерализованную форму кампилобактериоза необходимо отличать от сепсиса, вызванного другим возбудителем; хроническую форму – от токсоплазмоза, бруцеллеза, иерсиниозов и других хронических инфекционных заболеваний.
Лечение и профилактика кампилобактериоза
Объем лечебных мероприятий при кампилобактериозе зависит от формы и тяжести инфекции. При легкой степени локализованных форм кампилобактериоза этиотропная терапия не проводится: в этом случае ограничиваются назначением диеты, оральной регидратации, спазмолитиков, ферментов, биологических бактерийных препаратов для коррекции дисбактериоза кишечника. При среднетяжелом и тяжелом течении гастроинтестинальных форм кампилобактериоза, а также при генерализации инфекции показано применение антибактериальных препаратов, к которым чувствительны кампилобактеры (эритромицин, тетрациклин, доксициклин, хлорамфеникол, клиндамицин, фторхинолоны, аминогликозиды, макролиды, метронидазол, фуразолидон и др.) курсом 7-14 дней. Патогенетическая терапия кампилобактериоза предполагает инфузионное введение глюкозо-электролитных и полиионных растворов, назначение десенсибилизирующих средств. Лица, перенесшие кампилобактериоз, находятся на диспансерном наблюдении у инфекциониста в течение 1 месяца и подлежат двукратному бактериологическому обследованию.
При локализованных формах кампилобактериоза прогноз благоприятный. Осложнения возможны лишь при тяжелом течении заболевания и среди лиц с отягощенным сопутствующим фоном. При генерализованных формах, развивающихся у детей, беременных женщин, ослабленных пациентов, летальность может достигать 25-30%. Профилактика кампилобактериоза должна быть направлена на предупреждение инфицированности домашних животных и птиц; санитарный надзор за водоснабжением, режимом хранения и технологией переработки пищевых продуктов; обучение населения нормам личной гигиены и правилам приготовления пищи.
Пищевое отравление Campylobacter jejuni и его лечение
Campylobacter — один из трех самых частых возбудителей диареи в мире; 2 других — это ротавирус и Shigella (E.coli более распространена в слаборазвитых странах).
а) Источники. Виды Campylobacter обнаружены у многих животных, включая кур, индеек, свиней, крупный рогатый скот, овец, коз, собак, кошек, лошадей и грызунов. Диарея, вызываемая Campylobacter, распространяется через нехлорированную воду, а также сырое козье и коровье молоко. Прямая передача от человека человеку редка, хотя известно и бессимптомное носительство патогена. Недавнее доказательство его присутствия у гомосексуалистов, возможно, объясняет некоторые желудочно-кишечные расстройства, отмечаемые в этой группе пациентов.
б) Симптоматика. Инфекция, обусловленная C.jejuni, все больше сочетается с иммунными заболеваниями, включая синдром Гийена — Барре, реактивный артрит, синдром Рейтера и острый гломерулонефрит. Симптомы появляются через 1 — 8 сут после заражения (в среднем через 3 сут). Развивается водянистый или кровавый понос с лихорадкой, недомоганием, болями в животе и головной болью. У взрослых кампилобактериоз бывает клинически неотличим от шигеллеза, но у детей в возрасте до 5 лет при шигеллезе температура обычно более высокая (выше 38 °С). Кампилобактериоз может напоминать воспалительное заболевание кишечника.
Изредка при инфекции, вызванной Campylobacter, наблюдаются острый передний увеит, слабый реактивный артрит (с положительной реакцией на HLA-B27), миалгии, гемолитико-уремический синдром, узловатая эритема и крапивница. Средняя продолжительность расстройства 3-4 сут (общий диапазон 5 ч — 12 сут), но у иммунодефицитных пациентов его отдельные симптомы могут сохраняться дольше. К неврологическим осложнениям кампилобактериозного энтерита относятся припадки, менингоэнцефалит, субарахноидальное кровоизлияние, инсульт, субдуральная эмпиема и энцефалопатия. Септицемия, обусловленная C.jejuni, встречается у пациентов крайних возрастных групп и при иммунодефиците, хотя летальные исходы при ней наблюдаются главным образом у последних. До 30 % людей с таким сепсисом не страдают от симптомов гастроэнтерита.
в) Диагностика. Дифференциально-компрессионное УЗИ правой нижней области брюшной полости может демонстрировать утолщение стенки конца подвздошной и слепой кишки. Темнопольная микроскопия мазков кала иногда позволяет выявить характерные изогнутые грамотрицательные, неспорообразующие, тонкие, подвижные палочки (по-гречески Campylobacter значит "изогнутая палка"). При окрашивании по Граму необходимо применять контрастирование карболфуксином.
У пациентов с иммунодефицитом или интоксикацией полезно провести микробиологический посев крови. Сигмоскопия демонстрирует отечную гиперемическую слизистую оболочку с мелкими серыми в глубине афтозными язвами.
г) Лечение пищевого отравления Campylobacter jejuni. Без лечения кампилобактериозный энтероколит обычно проходит за 7 — 10 сут. Опиаты и антихолинергические средства противопоказаны, поскольку могут увеличить время прохождения содержимого по кишечнику или обострить симптоматику. Зачастую единственным лечением служит регидратация. Лучшим медикаментом считается эритромицина этилсукцинат; доза 400 мг 4 раза в день обычно сокращает срок выделения микроорганизма с калом. Эффективность этого средства с точки зрения облегчения симптоматики при использовании в первые 5 дней болезни остается под вопросом.


Редактор: Искандер Милевски. Дата обновления публикации: 18.3.2021
Читайте также:
